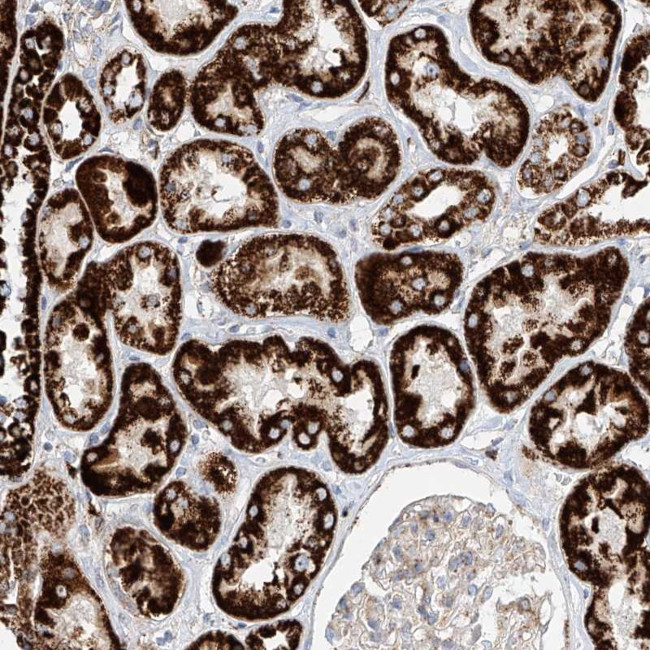
Cystatin 9 Antibody in Immunohistochemistry (Paraffin) (IHC (P))

Search
Invitrogen
Cystatin 9 Polyclonal Antibody
{{$productOrderCtrl.translations['antibody.pdp.commerceCard.promotion.promotions']}}
{{$productOrderCtrl.translations['antibody.pdp.commerceCard.promotion.viewpromo']}}
{{$productOrderCtrl.translations['antibody.pdp.commerceCard.promotion.promocode']}}: {{promo.promoCode}} {{promo.promoTitle}} {{promo.promoDescription}}. {{$productOrderCtrl.translations['antibody.pdp.commerceCard.promotion.learnmore']}}

Please note: We are reviewing Western blot images included in the antibody testing data in our catalog, including those provided by third parties. Unless expressly labeled or annotated as “raw-unedited”, Western blot images included in the antibody testing data in our catalog may have been edited, optimized or otherwise adjusted for presentation.
产品信息
PA5-56080
种属反应
宿主/亚型
分类
类型
抗原
偶联物
形式
浓度
规格
纯化类型
保存液
内含物
保存条件
运输条件
RRID
产品详细信息
Immunogen sequence: GGNNKIVQDP MFFATVEFAL NTFNVQSKEE HAYRLLRVLS SWREDSMDRK WRGKMVFSMN LQLRQTVCRK FEDDIDNCPF QESLELNNVR QGISFPQVHS CGCCMGCGV
Highest antigen sequence identity to the following orthologs: Mouse - 39%, Rat - 39%.
靶标信息
The cystatin superfamily encompasses proteins that contain multiple cystatin-like sequences. Some of the members are active cysteine protease inhibitors, while others have lost or perhaps never acquired this inhibitory activity. There are three inhibitory families in the superfamily, including the type 1 cystatins (stefins), type 2 cystatins and the kininogens. The type 2 cystatin proteins are a class of cysteine proteinase inhibitors found in a variety of human fluids and secretions, where they appear to provide protective functions. The cystatin locus on chromosome 20 contains the majority of the type 2 cystatin genes and pseudogenes. This gene is located in the cystatin locus and encodes a secreted protein that may play a role in hematopoietic differentiation or inflammation.
仅用于科研。不用于诊断过程。未经明确授权不得转售。